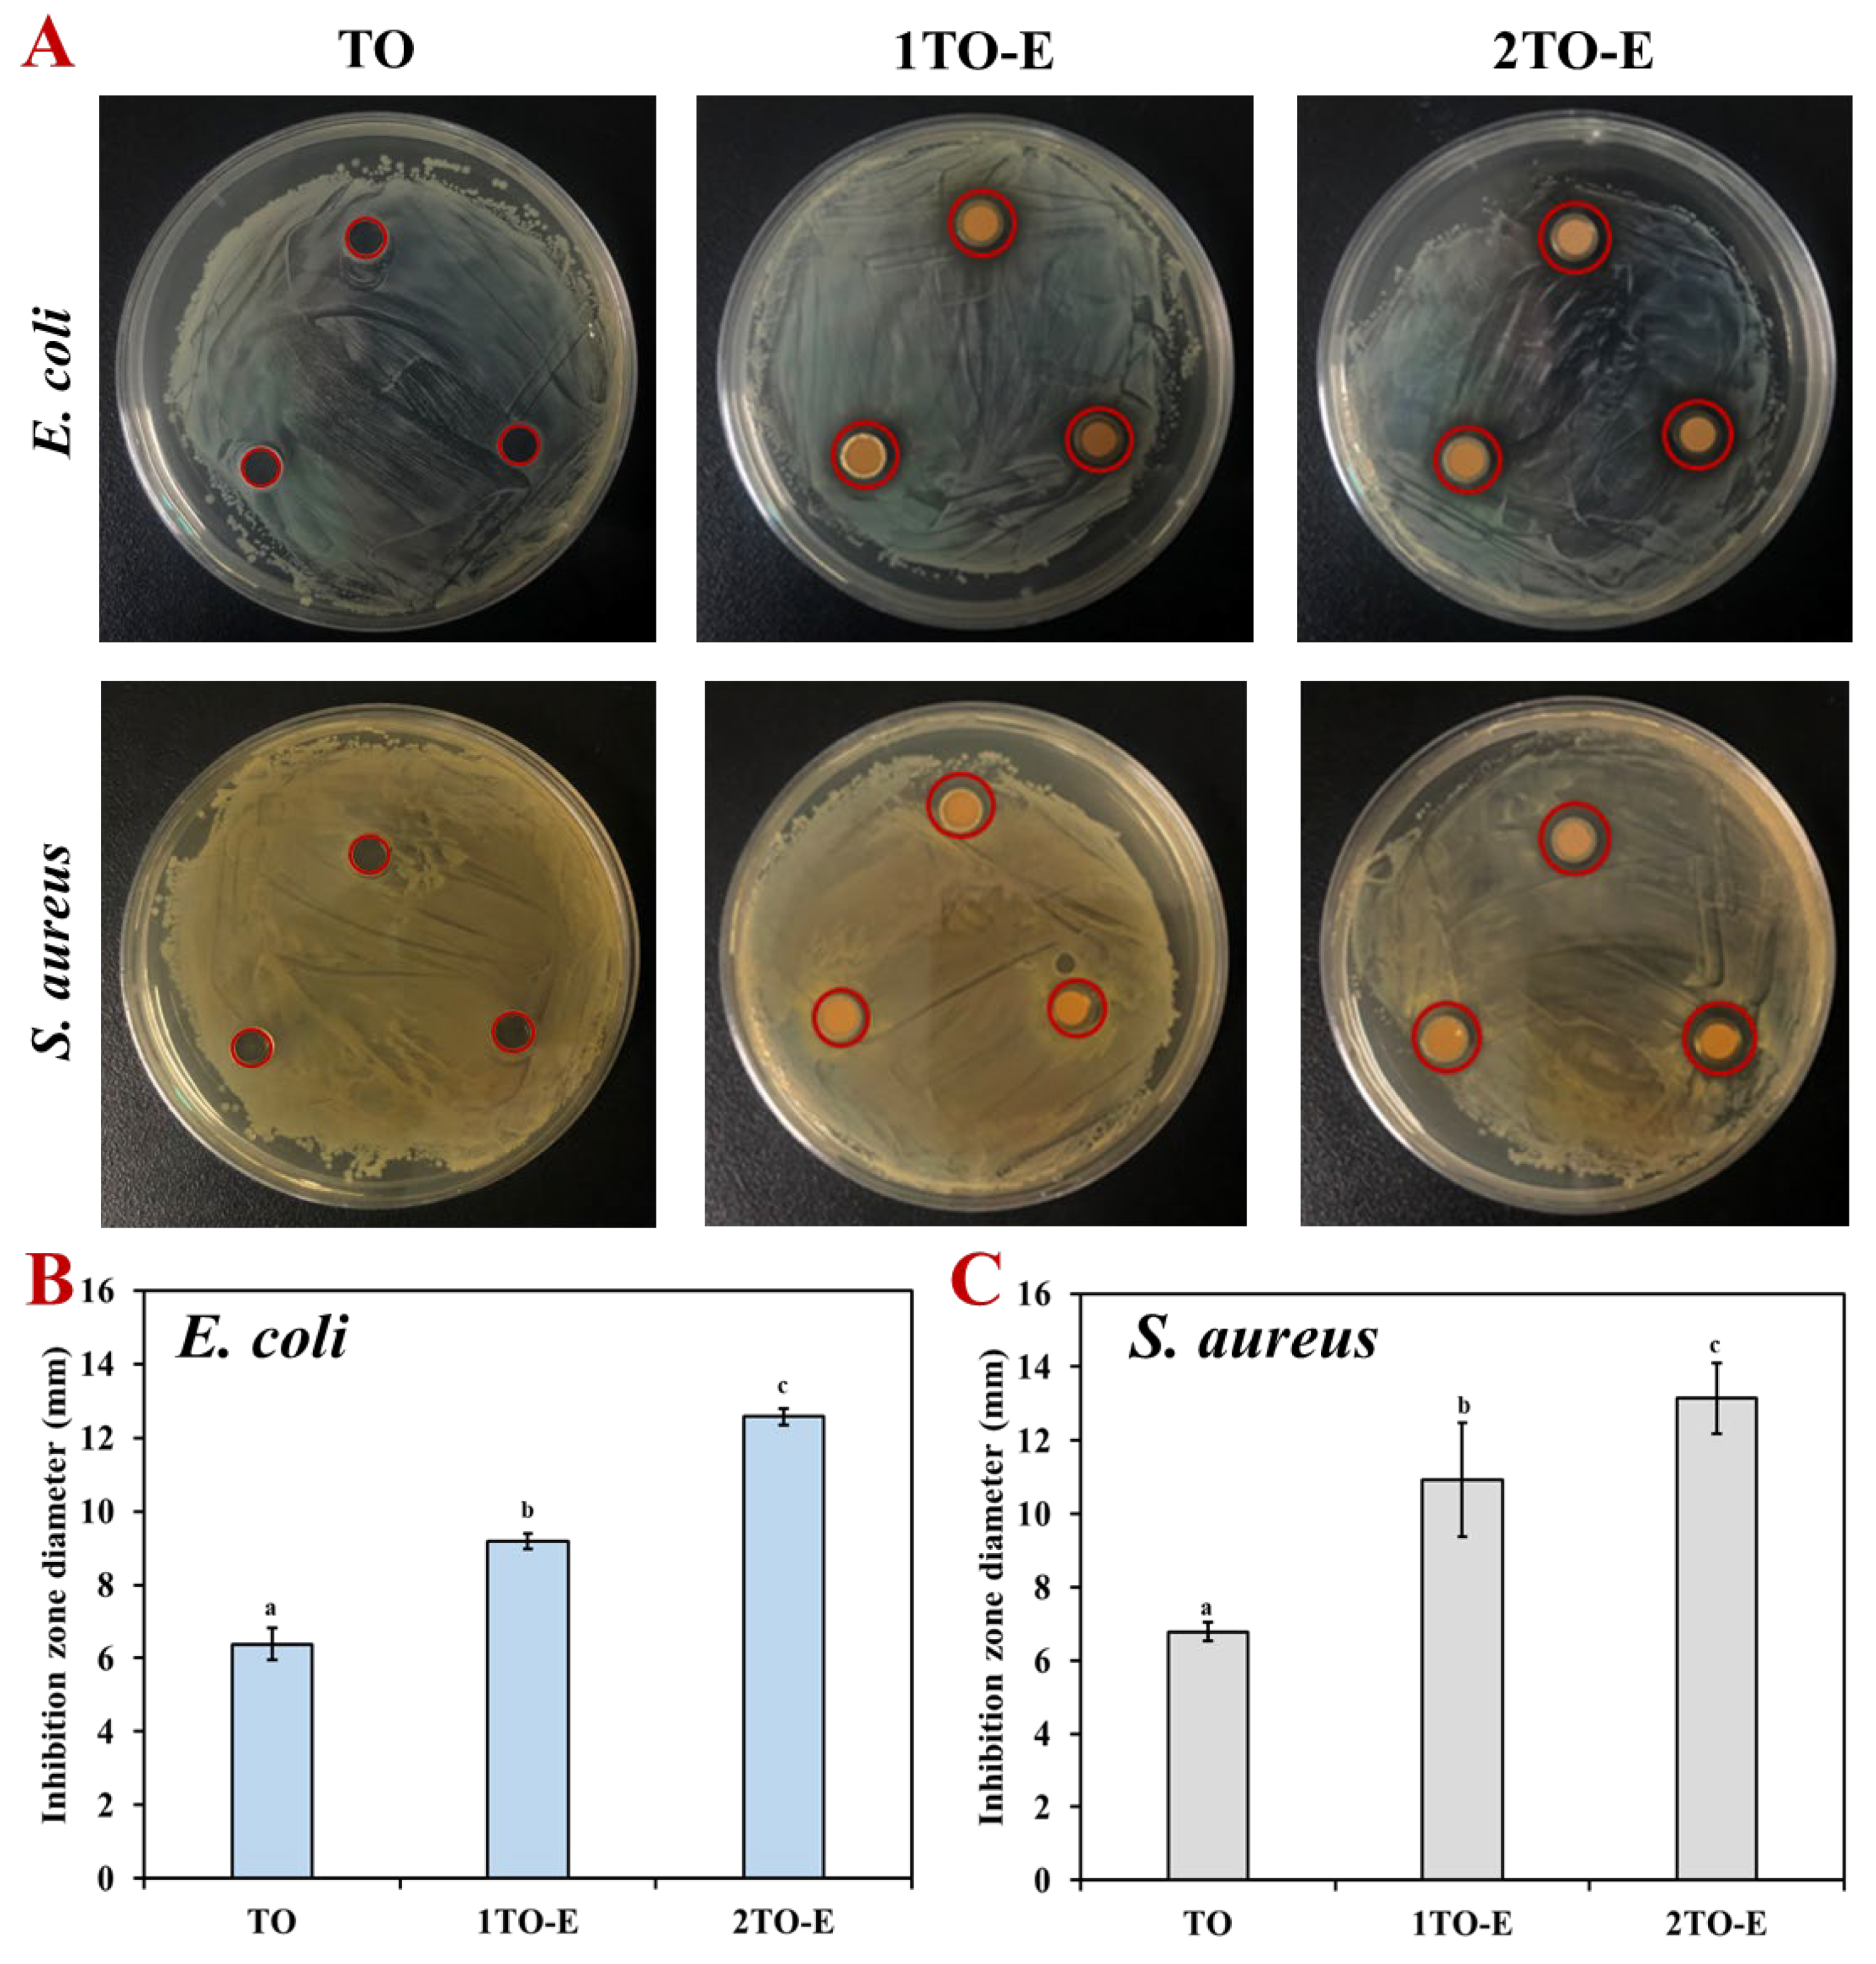
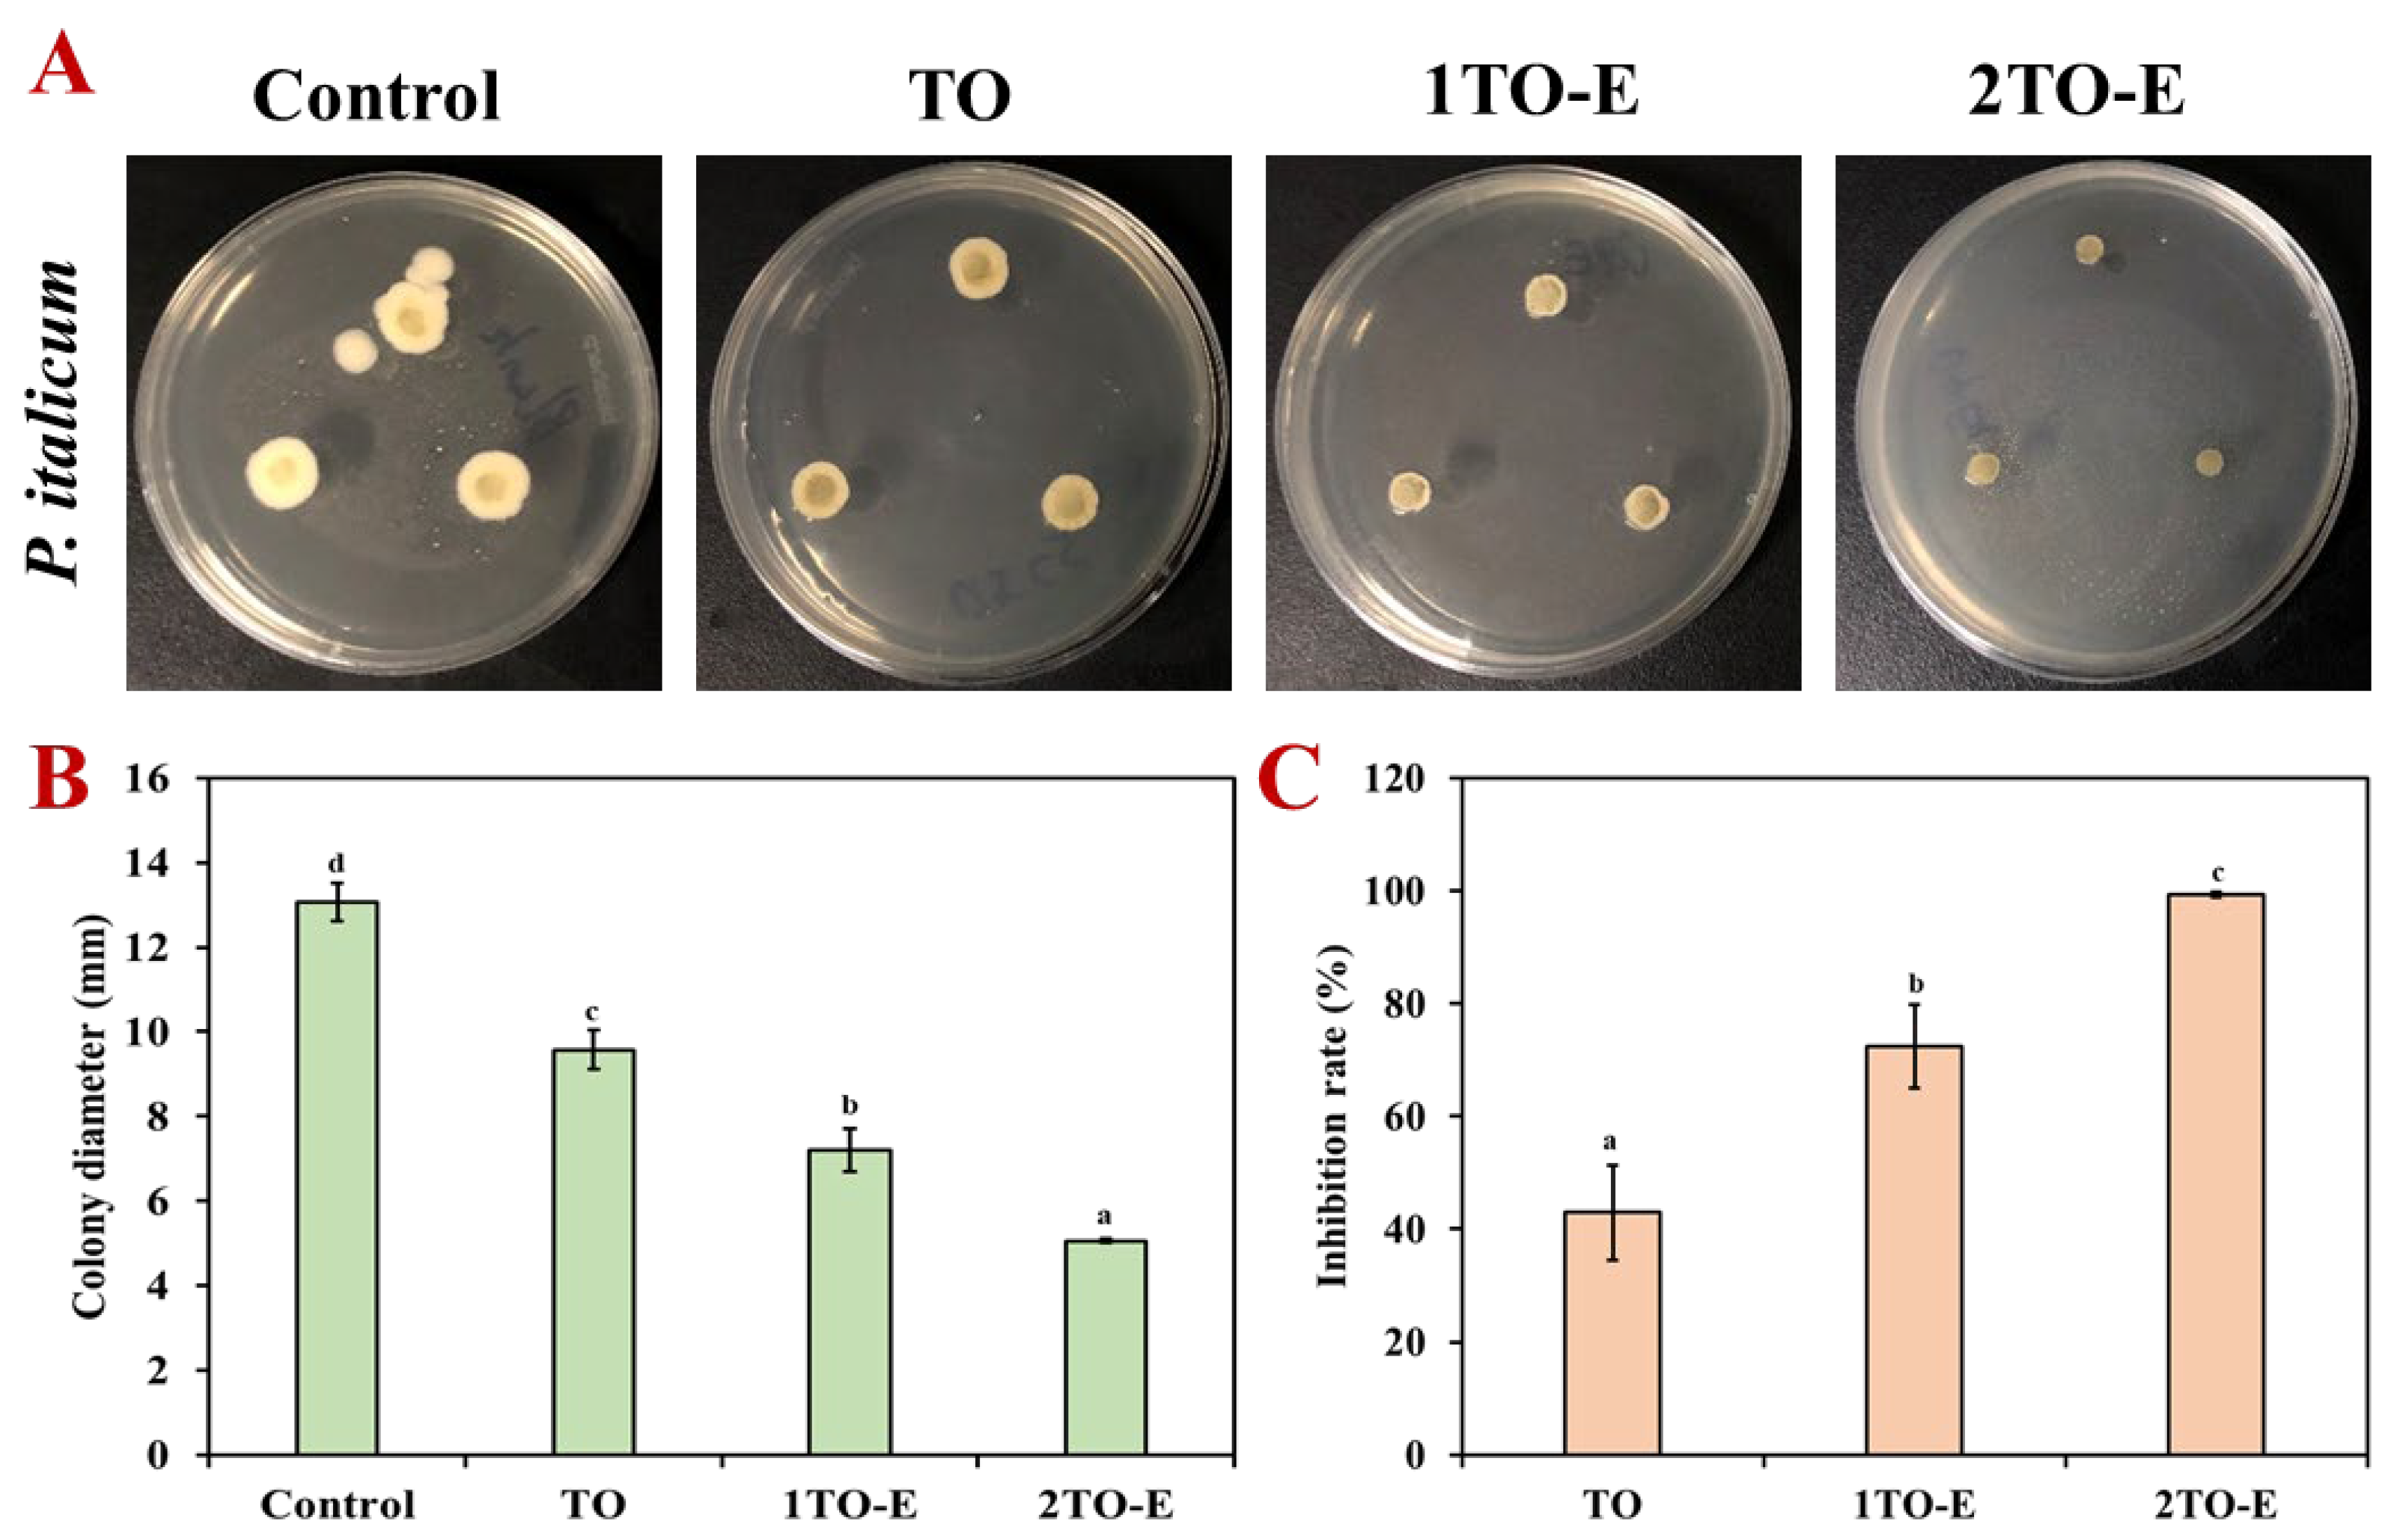

Ultrasound-Assisted Preparation of Chitosan Oligosaccharide-Stabilized Thyme Oil-in-Water Nanoemulsions: Enhanced Storage Stability and Antimicrobial Properties
Abstract
1. Introduction
2. Materials and Methods
2.1. Materials
2.2. Preparation of the Thyme Oil Emulsion
2.3. Physicochemical Characterization of Thyme Oil Emulsion
2.3.1. Droplet Size and Zeta Potential Measurement
2.3.2. Microscopy Observation
2.3.3. Encapsulation Efficiency Determination
2.4. Antioxidant Quenching Activity of Thyme Oil Emulsion
2.5. Antimicrobial Activity of Thyme Oil Emulsion
2.5.1. Determination of Minimum Inhibitory Concentration (MIC) and Minimum Bactericidal Concentration (MBC)
2.5.2. Determination of the Antibacterial Inhibition Zone of the TO Emulsion
2.5.3. Inhibitory Effect of the Emulsion on Mycelial Growth of P. italicum
2.6. Statistical Analysis
3. Results and Discussion
3.1. Formation of Thyme Oil-in-Water Emulsions
3.2. Storage Stability of Thyme Oil-in-Water Emulsions
3.2.1. Appearance and Droplet Size Change of TO Emulsions
3.2.2. Distribution of Droplets During Storage of TO Emulsions
3.3. Antioxidant Activity of Thyme Oil-in-Water Emulsions
3.4. Antimicrobial Activity of Thyme Oil-in-Water Emulsions
3.4.1. MIC and MBC Evaluation of TO Emulsions
3.4.2. Inhibition Zone Evaluation of TO Emulsions
3.4.3. Inhibitory Effect of TO Emulsions on Mycelial Growth
4. Conclusions
Supplementary Materials
Author Contributions
Funding
Institutional Review Board Statement
Informed Consent Statement
Data Availability Statement
Conflicts of Interest
References
- Chang, Y.; McLandsborough, L.; McClements, D.J. Physical properties and antimicrobial efficacy of thyme oil nanoemulsions: Influence of ripening inhibitors. J. Agric. Food Chem. 2012, 60, 12056–12063. [Google Scholar] [CrossRef]
- Ribeiro, S.; Almeida, R.; Batista, L.; Lima, J.; Sarinho, A.; Nascimento, A.; Lisboa, H. Investigation of Guar Gum and Xanthan Gum Influence on Essential Thyme Oil Emulsion Properties and Encapsulation Release Using Modeling Tools. Foods 2024, 13, 816. [Google Scholar] [CrossRef] [PubMed]
- Romulo, A.; Anjani, V.S.; Wardana, A.A. Enhancing Antimicrobial Activity of Thyme Essential Oil Through Cellulose Nano Crystals-Stabilized Pickering Emulsions. Foods 2024, 13, 3706. [Google Scholar] [CrossRef] [PubMed]
- Correa, A.N.R.; Ferreira, C.D. Essential oil for the control of fungi, bacteria, yeasts and viruses in food: An overview. Crit. Rev. Food Sci. Nutr. 2023, 63, 8960–8974. [Google Scholar] [CrossRef] [PubMed]
- Yang, T.; Qin, W.; Zhang, Q.; Luo, J.; Lin, D.; Chen, H. Essential-oil capsule preparation and its application in food preservation: A review. Food Rev. Int. 2022, 39, 4124–4158. [Google Scholar] [CrossRef]
- Zhao, R.; Chen, J.; Yu, S.; Niu, R.; Yang, Z.; Wang, H.; Cheng, H.; Ye, X.; Liu, D.; Wang, W. Active chitosan/gum Arabic-based emulsion films reinforced with thyme oil encapsulating blood orange anthocyanins: Improving multi-functionality. Food Hydrocoll. 2023, 134, 108094. [Google Scholar] [CrossRef]
- Phyo, H.M.; Al-Maqtari, Q.A.; Mi, S.; Du, Y.; Khalid, M.U.; Yao, W. Ultrasound-assisted fabrication of chitosan-hydroxypropyl methylcellulose nanoemulsions loaded with thymol and cinnamaldehyde: Physicochemical properties, stability, and antifungal activity. Int. J. Biol. Macromol. 2024, 281, 136278. [Google Scholar] [CrossRef]
- Zhang, Y.; Zhong, Q. Physical and antimicrobial properties of neutral nanoemulsions self-assembled from alkaline thyme oil and sodium caseinate mixtures. Int. J. Biol. Macromol. 2020, 148, 1046–1052. [Google Scholar] [CrossRef]
- Hanan, E.; Dar, A.H.; Shams, R.; Goksen, G. New insights into essential oil nano emulsions loaded natural biopolymers recent development, formulation, characterization and packaging applications: A comprehensive review. Int. J. Biol. Macromol. 2024, 280, 135751. [Google Scholar] [CrossRef]
- Garavand, F.; Jalai-Jivan, M.; Assadpour, E.; Jafari, S.M. Encapsulation of phenolic compounds within nano/microemulsion systems: A review. Food Chem. 2021, 364, 130376. [Google Scholar] [CrossRef]
- Zhao, R.; Song, R.; Sun, G.; Liu, S.; Li, B.; Cao, Y.; Li, Y. Cutoff Ostwald ripening stability of eugenol-in-water emulsion by co-stabilization method and antibacterial activity evaluation. Food Hydrocoll. 2020, 107, 105925. [Google Scholar] [CrossRef]
- Li, B.; Cui, J.; Xu, T.; Xu, Y.; Long, M.; Li, J.; Liu, M.; Yang, T.; Du, Y.; Xu, Q. Advances in the preparation, characterization, and biological functions of chitosan oligosaccharide derivatives: A review. Carbohydr. Polym. 2024, 332, 121914. [Google Scholar] [CrossRef]
- Milkova, V. Electrosteric stabilization of oil/water emulsions by adsorption of chitosan oligosaccharides—An electrokinetic study. Carbohydr. Polym. 2021, 265, 118072. [Google Scholar] [CrossRef]
- Sorasitthiyanukarn, F.N.; Muangnoi, C.; Rojsitthisak, P.; Rojsitthisak, P. Chitosan oligosaccharide/alginate nanoparticles as an effective carrier for astaxanthin with improving stability, in vitro oral bioaccessibility, and bioavailability. Food Hydrocoll. 2022, 124, 107246. [Google Scholar] [CrossRef]
- Chen, H.; Zhao, R.; Hu, J.; Wei, Z.; McClements, D.J.; Liu, S.; Li, B.; Li, Y. One-Step Dynamic Imine Chemistry for Preparation of Chitosan-Stabilized Emulsions Using a Natural Aldehyde: Acid Trigger Mechanism and Regulation and Gastric Delivery. J. Agric. Food Chem. 2020, 68, 5412–5425. [Google Scholar] [CrossRef] [PubMed]
- Yue, M.; Huang, M.; Zhu, Z.; Huang, T.; Huang, M. Effect of ultrasound assisted emulsification in the production of Pickering emulsion formulated with chitosan self-assembled particles: Stability, macro, and micro rheological properties. LWT 2022, 154, 112595. [Google Scholar] [CrossRef]
- Zhao, R.; Guo, H.; Yan, T.; Li, J.; Xu, W.; Deng, Y.; Zhou, J.; Ye, X.; Liu, D.; Wang, W. Fabrication of multifunctional materials based on chitosan/gelatin incorporating curcumin-clove oil emulsion for meat freshness monitoring and shelf-life extension. Int. J. Biol. Macromol. 2022, 223, 837–850. [Google Scholar] [CrossRef]
- Niu, J.; Lin, Q.; Li, X.; McClements, D.J.; Ji, H.; Jin, Z.; Qiu, C. Pickering emulsions stabilized by essential oil-tannin-chitosan particles: Microstructure, stability, antibacterial activity, and antioxidant activity. Food Hydrocoll. 2024, 154, 110145. [Google Scholar] [CrossRef]
- Wang, D.; Liu, L.; Chen, H.; Chi, H.; Xiang, W.; Zhang, Q.; Tang, J.; Zhang, X. Fabrication and characterization of Zanthoxylum schinifolium essential oil Pickering emulsion stabilized by bacterial cellulose nanofibrils/whey protein isolate complexes and fortified with cinnamaldehyde. LWT 2024, 210, 116829. [Google Scholar] [CrossRef]
- Li, Y.; Zhao, R.; Li, Y.; Zhou, Z. Limonin Enhances the Antifungal Activity of Eugenol Nanoemulsion against Penicillium italicum In Vitro and In Vivo Tests. Microorganisms 2021, 9, 969. [Google Scholar] [CrossRef]
- Yang, Y.; Gupta, V.K.; Amiri, H.; Pan, J.; Aghbashlo, M.; Tabatabaei, M.; Rajaei, A. Recent developments in improving the emulsifying properties of chitosan. Int. J. Biol. Macromol. 2023, 239, 124210. [Google Scholar] [CrossRef]
- Zhu, Y.; Zhu, Y.; Chen, G.; Xiao, H.; Wang, Y.; Tan, C. Sonochemical high internal phase emulsions stabilized solely by intermolecular hydrogen bonds of chitosan. Food Hydrocoll. 2025, 162, 110860. [Google Scholar] [CrossRef]
- Bai, L.; Geng, S.; Zhou, Y.; Ma, H.; Liu, B. Ultrasound-assisted fabrication and stability evaluation of okra seed protein stabilized nanoemulsion. Ultrason. Sonochem. 2024, 104, 106807. [Google Scholar] [CrossRef] [PubMed]
- Zhao, R.; Chen, T.; Li, Y.; Chen, L.; Xu, Y.; Chi, X.; Yu, S.; Wang, W.; Liu, D.; Zhu, B.; et al. Biocompatible hydrophobic cross-linked cyclodextrin-based metal-organic framework as quercetin nanocarrier for enhancing stability and controlled release. Food Chem. 2024, 448, 139167. [Google Scholar] [CrossRef] [PubMed]
- Song, Y.; Xiao, J.; Li, L.; Wan, L.; Li, B.; Zhang, X. Ultrasound treatment of crystalline oil-in-water emulsions stabilized by sodium caseinate: Impact on emulsion stability through altered crystallization behavior in the oil globules. Ultrason. Sonochem. 2024, 106, 106897. [Google Scholar] [CrossRef] [PubMed]
- Li, J.; Wang, S.; Wang, H.; Cao, W.; Lin, H.; Qin, X.; Chen, Z.; Gao, J.; Wu, L.; Zheng, H. Effect of ultrasonic power on the stability of low-molecular-weight oyster peptides functional-nutrition W(1)/O/W(2) double emulsion. Ultrason. Sonochem. 2023, 92, 106282. [Google Scholar] [CrossRef]
- Zhang, X.; Wang, Y.; Wang, D.; Tang, J.; Xu, M. Synergistic stabilization of garlic essential oil nanoemulsions by carboxymethyl chitosan/Tween 80 and application for coating preservation of chilled fresh pork. Int. J. Biol. Macromol. 2024, 266, 131370. [Google Scholar] [CrossRef]
- Jayari, A.; Donsi, F.; Ferrari, G.; Maaroufi, A. Nanoencapsulation of Thyme Essential Oils: Formulation, Characterization, Storage Stability, and Biological Activity. Foods 2022, 11, 1858. [Google Scholar] [CrossRef]
- Karsli, G.T.; Sahin, S.; Oztop, M.H. High-Pressure-Homogenized Clove and Thyme Oil Emulsions: Formulation, Stability, and Antioxidant Capacity. ACS Food Sci. Technol. 2022, 2, 1832–1839. [Google Scholar] [CrossRef]
- Tiang, S.S.L.; Low, L.E.; Ali, I.; Zhou, L.; Goh, B.-H.; Gew, L.T.; Tang, S.Y. Recent advances in ultrasonic cavitation technologies for emulsion preparation: A mini review. Curr. Opin. Chem. Eng. 2024, 45, 101046. [Google Scholar] [CrossRef]
- Li, S.; Sun, J.; Yan, J.; Zhang, S.; Shi, C.; McClements, D.J.; Liu, X.; Liu, F. Development of antibacterial nanoemulsions incorporating thyme oil: Layer-by-layer self-assembly of whey protein isolate and chitosan hydrochloride. Food Chem. 2021, 339, 128016. [Google Scholar] [CrossRef]
- Li, H.; Liu, M.; Han, S.; Hua, S.; Zhang, H.; Wang, J.; Xia, N.; Liu, Y.; Meng, D. Edible chitosan-based Pickering emulsion coatings: Preparation, characteristics, and application in strawberry preservation. Int. J. Biol. Macromol. 2024, 264, 130672. [Google Scholar] [CrossRef]
- Liu, T.; Liu, L. Fabrication and characterization of chitosan nanoemulsions loading thymol or thyme essential oil for the preservation of refrigerated pork. Int. J. Biol. Macromol. 2020, 162, 1509–1515. [Google Scholar] [CrossRef]
- Guo, Y.; Zhang, X.; Wang, X.; Zhang, L.; Xu, Z.; Sun, D. Nanoemulsions Stable against Ostwald Ripening. Langmuir 2024, 40, 1364–1372. [Google Scholar] [CrossRef] [PubMed]
- Kim, J.; Noh, Y.; McClements, D.J.; Choi, S.J. Impact of hydrophilic substances on Ostwald ripening in emulsions stabilized by varied hydrophilic group surfactants. NPJ Sci. Food 2024, 8, 76. [Google Scholar] [CrossRef] [PubMed]
- Xu, F.; Shi, Y.; Li, B.; Liu, C.; Zhang, Y.; Zhong, J. Characterization, Stability and Antioxidant Activity of Vanilla Nano-Emulsion and Its Complex Essential Oil. Foods 2024, 13, 801. [Google Scholar] [CrossRef] [PubMed]
- Liang, D.; Feng, B.; Li, N.; Su, L.; Wang, Z.; Kong, F.; Bi, Y. Preparation, characterization, and biological activity of Cinnamomum cassia essential oil nano-emulsion. Ultrason. Sonochem. 2022, 86, 106009. [Google Scholar] [CrossRef]
- Rui, L.; Li, Y.; Wu, X.; Wang, Y.; Xia, X. Effect of clove essential oil nanoemulsion on physicochemical and antioxidant properties of chitosan film. Int. J. Biol. Macromol. 2024, 263, 130286. [Google Scholar] [CrossRef]
- Fu, H.; Huang, R.; Li, J.; Lin, Z.; Wei, F.; Lin, B. Multifunctional cinnamaldehyde-tannic acid nano-emulsion/chitosan composite film for mushroom preservation. Food Hydrocoll. 2023, 145, 109111. [Google Scholar] [CrossRef]
- Rout, S.; Tambe, S.; Deshmukh, R.K.; Mali, S.; Cruz, J.; Srivastav, P.P.; Amin, P.D.; Gaikwad, K.K.; Andrade, E.H.D.A.; Oliveira, M.S.D. Recent trends in the application of essential oils: The next generation of food preservation and food packaging. Trends Food Sci. Technol. 2022, 129, 421–439. [Google Scholar] [CrossRef]
- Zhong, W.; Li, D.; Li, L.; Yu, S.; Pang, J.; Zhi, Z.; Wu, C. pH-responsive Pickering emulsion containing citrus essential oil stabilized by zwitterionically charged chitin nanofibers: Physicochemical properties and antimicrobial activity. Food Chem. 2024, 433, 137388. [Google Scholar] [CrossRef]
- Hedayati, S.; Tarahi, M.; Iraji, A.; Hashempur, M.H. Recent developments in the encapsulation of lavender essential oil. Adv. Colloid Interface Sci. 2024, 331, 103229. [Google Scholar] [CrossRef]
- Li, Q.; Chen, Z.; Zeng, L.; Bi, Y.; Kong, F.; Wang, Z.; Tan, S. Characterization, in-vitro digestion, antioxidant, anti-hyperlipidemic and antibacterial activities of Zanthoxylum bungeanum Maxim essential oil nano-emulsion. Food Biosci. 2023, 56, 103082. [Google Scholar] [CrossRef]
- Liu, Q.; Wang, Z.; Mukhamadiev, A.; Feng, J.; Gao, Y.; Zhuansun, X.; Han, R.; Chong, Y.; Jafari, S.M. Formulation optimization and characterization of carvacrol-loaded nanoemulsions: In vitro antibacterial activity/mechanism and safety evaluation. Ind. Crops. Prod. 2022, 181, 114816. [Google Scholar] [CrossRef]
- Yu, H.; Huang, G.; Ma, Y.; Liu, Y.; Huang, X.; Zheng, Q.; Yue, P.; Yang, M. Cellulose nanocrystals based clove oil Pickering emulsion for enhanced antibacterial activity. Int. J. Biol. Macromol. 2021, 170, 24–32. [Google Scholar] [CrossRef]

| Time | Power | ||
|---|---|---|---|
| 300 W | 450 W | 600 W | |
| 5 min | 719.08 ± 4.87 f | 404.75 ± 3.11 c | 385.69 ± 4.42 b |
| 10 min | 590.56 ± 4.33 e | 224.27 ± 2.72 a | 220.74 ± 3.89 a |
| 20 min | 520.80 ± 2.29 d | 226.25 ± 6.01 a | 222.37 ± 2.86 a |
| Microbial Strain | Antimicrobial Component | MIC (μg/mL) | MBC (μg/mL) |
|---|---|---|---|
| E. coli | 2%TO in ethanol | 625.0 | 1250.0 |
| 2TO-E | 312.5 | 312.5 | |
| S. aureus | 2%TO in ethanol | 625.0 | 625.0 |
| 2TO-E | 312.5 | 312.5 | |
| P. italicum | 2%TO in ethanol | 625.0 | 625.0 |
| 2TO-E | 312.5 | 312.5 |
Disclaimer/Publisher’s Note: The statements, opinions and data contained in all publications are solely those of the individual author(s) and contributor(s) and not of MDPI and/or the editor(s). MDPI and/or the editor(s) disclaim responsibility for any injury to people or property resulting from any ideas, methods, instructions or products referred to in the content. |
© 2025 by the authors. Licensee MDPI, Basel, Switzerland. This article is an open access article distributed under the terms and conditions of the Creative Commons Attribution (CC BY) license (https://creativecommons.org/licenses/by/4.0/).
Share and Cite
Wang, H.; Dong, Q.; Wang, W.; Chen, J.; Wang, W.; Fang, Z.; Zhao, R. Ultrasound-Assisted Preparation of Chitosan Oligosaccharide-Stabilized Thyme Oil-in-Water Nanoemulsions: Enhanced Storage Stability and Antimicrobial Properties. Foods 2025, 14, 2930. https://doi.org/10.3390/foods14172930
Wang H, Dong Q, Wang W, Chen J, Wang W, Fang Z, Zhao R. Ultrasound-Assisted Preparation of Chitosan Oligosaccharide-Stabilized Thyme Oil-in-Water Nanoemulsions: Enhanced Storage Stability and Antimicrobial Properties. Foods. 2025; 14(17):2930. https://doi.org/10.3390/foods14172930
Chicago/Turabian StyleWang, Hao, Qirong Dong, Wenyue Wang, Jin Chen, Wenjun Wang, Zhongxiang Fang, and Runan Zhao. 2025. "Ultrasound-Assisted Preparation of Chitosan Oligosaccharide-Stabilized Thyme Oil-in-Water Nanoemulsions: Enhanced Storage Stability and Antimicrobial Properties" Foods 14, no. 17: 2930. https://doi.org/10.3390/foods14172930
APA StyleWang, H., Dong, Q., Wang, W., Chen, J., Wang, W., Fang, Z., & Zhao, R. (2025). Ultrasound-Assisted Preparation of Chitosan Oligosaccharide-Stabilized Thyme Oil-in-Water Nanoemulsions: Enhanced Storage Stability and Antimicrobial Properties. Foods, 14(17), 2930. https://doi.org/10.3390/foods14172930

